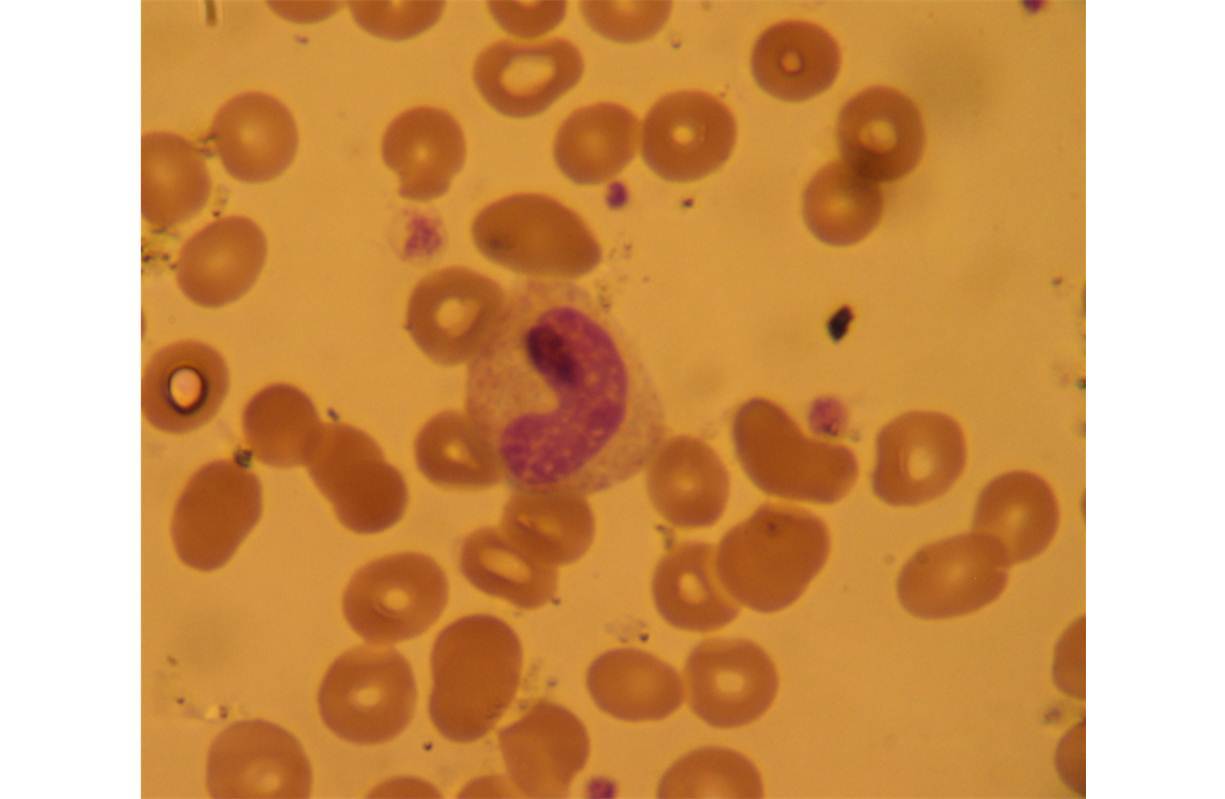

1
Q
A
- Band Cell
- “baby neutrophil”
2
Q

A
- Basophil
- “unknown stranger”
3
Q

A
- Eosinophil
- “allergy slayer”
4
Q

A
- Hyper Segmented Neutrophil
- “senior citizen”
5
Q

A
- Lymphocyte
- “guard dog”
6
Q

A
- Monocyte
- “scavenger”
7
Q

A
- Segmented Neutrophil
- “adult”
8
Q

A
size comparison
9
Q
5 White Blood Cells in order of most common to least common
A
- segmented neutrophil
- lymphocyte
- monocyte
- eosinophil
- basophil
10
Q
Which WBC’s are Granulocytes?
A
- segmented neutrophil
- eosinophil
- basophil
11
Q
Which WBC’s are Agranulocytes?
A
- lymphocyte
- monocyte
12
Q
What is Agranulocyte?
A
has no granules in cytoplasm
13
Q
What is Granulocyte?
A
have granules in cytoplasm
14
Q
What color will Basophils stain?
A
Blue
15
Q
What color will Eosinophils stain?
A
Red
16
Q
What color will Segmented Neutrophils stain?
A
- clear
- not visible when stained
17
Q
What is the Segmented Neutrophil?
A
- “The Adult”
- most common in blood
- primary WBC found in pus
- first responder to either trauma or bacterial infection
- can reach inflammation site within minutes
18
Q
How long do Segmented Neutrophils live?
A
about 5 days
19
Q
What is the Band Cell?
A
- “The Baby Neutrophil”
- sometimes called Stab Cell
- immature neutrophil
- indicates there is a high demand for neutrophils during inflammatory response
20
Q
What is the Hyper Segmented Neutrophil?
A
- The Senior Citizen
- has atleast 5 lobes
- has been in circulation for a while
- usually indication of iron deficency anemia
21
Q
What is the Lymphocyte?
A
- The Guard Dog
- has large nucleus
- second most common
- defend against:tumors, bacteria, viruses and foreign invaders
22
Q
What are the 3 types of Lymphocytes?
A
- T cells: long life (years)
- B cells: short life (months at longest)
- NK cells
23
Q
What is the Monocyte?
A
- The Scavenger
- 3rd most common
- have vacuoles used to phagocytize foreign debris/invaders
- if left bloodstream :Macrophage!
- only live a few days
- die after phagocytizing
24
Q
What is Eosinophil?
A
- The Allergy Slayer
- 4th most common
- primary function: defense against parasites and allergies
- attracted to histamines and other things released during basophilic degranulation
- histamine neutrolizer!!!
25
What is the life span of Eosiinophil?
- 8-12 hours in circulation
- 8-12 days in tissue if not required to respond to invader
26
What is Basophil?
- The Unkown Stranger
- least common
- can migrate to tissue if needed
- no real job
- granules are histamine and heparin used to attract eosinophils to help respond to invaders
- live few days
27


